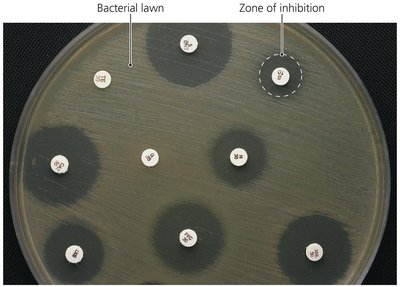
Kirby-Bauer test showing zones of inhibition
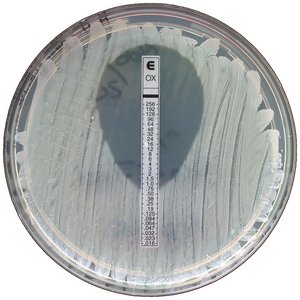
Etest combining Kirby-Bauer and MIC

Back
BackControlling Microbial Growth in the Body: Antimicrobial Drugs
Study Guide - Smart Notes

Controlling Microbial Growth in the Body: Antimicrobial Drugs
Introduction
Antimicrobial drugs are essential tools in modern medicine, used to control and eliminate microbial pathogens within the human body. Their development and clinical use have revolutionized the treatment of infectious diseases, but their application requires careful consideration of mechanisms, effectiveness, safety, and the potential for resistance.
Mechanisms of Antimicrobial Action
Overview of Mechanisms
Antimicrobial drugs target specific structures or functions in microbial cells, minimizing harm to human cells. The main mechanisms include:
Inhibition of Cell Wall Synthesis: Prevents bacteria from forming functional cell walls, leading to cell lysis (e.g., penicillins, cephalosporins).
Inhibition of Protein Synthesis: Targets bacterial ribosomes, disrupting protein production (e.g., tetracyclines, erythromycin).
Disruption of Cytoplasmic Membranes: Damages membrane integrity, causing cell contents to leak (e.g., polymyxins, antifungals).
Inhibition of Metabolic Pathways: Blocks key enzymatic reactions unique to microbes (e.g., sulfonamides inhibit folic acid synthesis).
Inhibition of Nucleic Acid Synthesis: Interferes with DNA or RNA synthesis (e.g., quinolones, rifampin).
Prevention of Virus Attachment, Entry, or Uncoating: Blocks viral entry or uncoating in host cells (e.g., pleconaril, arildone).
Example: Beta-lactam antibiotics inhibit cell wall synthesis by targeting the enzyme transpeptidase, essential for peptidoglycan cross-linking in bacteria.
Prevention of Virus Attachment, Entry, or Uncoating
Attachment antagonists block viral proteins or host receptors, preventing infection.
Pleconaril blocks viral attachment; arildone prevents viral uncoating.
Clinical Considerations in Prescribing Antimicrobial Drugs
Ideal Antimicrobial Agent
The ideal antimicrobial drug should:
Be readily available and inexpensive
Be chemically stable and easily administered
Be nontoxic and nonallergenic
Be selectively toxic against a wide range of pathogens
Spectrum of Action
The spectrum of action refers to the range of pathogens a drug affects:
Narrow-spectrum drugs target a limited group of microbes.
Broad-spectrum drugs target a wide variety of organisms, but may disrupt normal flora and lead to superinfections.
Drug | Prokaryotes | Eukaryotes | Viruses |
|---|---|---|---|
Isoniazid | Mycobacteria | ||
Polymyxin | Gram-negative bacteria | ||
Penicillin | Gram-positive bacteria | ||
Azoles | Fungi | ||
Nicosamide | Helminths | ||
Arildone, Ribavirin, Acyclovir | Viruses | ||
Streptomycin, Erythromycin, Tetracycline, Sulfonamides | Various bacteria |

Effectiveness of Antimicrobial Drugs
Effectiveness is determined by laboratory tests:
Diffusion susceptibility (Kirby-Bauer) test: Measures zones of inhibition around antibiotic disks on an agar plate.
Minimum inhibitory concentration (MIC) test: Determines the lowest concentration of drug that inhibits visible growth.
Minimum bactericidal concentration (MBC) test: Identifies the lowest concentration that kills the microbe.

Routes of Administration
Antimicrobial drugs can be administered in several ways, affecting their distribution and effectiveness:
Topical: Applied to skin for external infections.
Oral: Taken by mouth, convenient but may have lower and variable absorption.
Intramuscular (IM): Injected into muscle, allows moderate absorption.
Intravenous (IV): Delivered directly into bloodstream, provides rapid and high drug levels.

Safety and Side Effects
Toxicity: Some drugs may harm kidneys, liver, or nerves; therapeutic index and window guide safe dosing.
Allergies: Rare but potentially life-threatening reactions (e.g., anaphylactic shock).
Disruption of normal microbiota: Can lead to secondary infections or superinfections, especially in hospitalized patients.

Resistance to Antimicrobial Drugs
Development of Resistance in Populations
Microbial resistance arises through genetic changes:
Natural resistance: Some microbes are inherently resistant to certain drugs.
Acquired resistance: Occurs via mutations or acquisition of resistance (R) plasmids through transformation, transduction, or conjugation.

Mechanisms of Resistance
Microbes employ several strategies to resist antimicrobial drugs:
Produce enzymes (e.g., beta-lactamase) that destroy or inactivate drugs.
Alter drug entry or efflux pumps to prevent drug accumulation.
Modify drug targets to reduce binding.
Change metabolic pathways to bypass drug action.
Form biofilms that impede drug penetration.
Produce proteins (e.g., MfpA in Mycobacterium tuberculosis) that protect drug targets.

Multiple Resistance and Cross Resistance
Multiple resistance: Pathogens may become resistant to several drugs, especially in healthcare settings where R plasmids are exchanged.
Cross resistance: Resistance to one drug confers resistance to similar drugs.
Multiple-drug-resistant pathogens: Resistant to at least three antimicrobial agents.
Retarding Resistance
Strategies to slow the development of resistance include:
Maintaining high drug concentrations in patients to ensure complete pathogen elimination.
Using drug combinations (synergism enhances effect; antagonism reduces effect).
Limiting antimicrobial use to necessary cases.
Developing new drugs and modifying existing ones (second- and third-generation drugs).
Designing drugs that target unique microbial proteins.

Summary Table: Key Laboratory Tests for Antimicrobial Effectiveness
Test | Purpose | Interpretation |
|---|---|---|
Kirby-Bauer (Diffusion Susceptibility) | Measures zone of inhibition | Larger zone = greater sensitivity |
MIC Test | Finds lowest inhibitory concentration | Lowest concentration with no visible growth |
MBC Test | Finds lowest bactericidal concentration | Lowest concentration that kills bacteria |
Conclusion
Understanding the mechanisms, clinical considerations, and resistance patterns of antimicrobial drugs is crucial for effective and safe treatment of infectious diseases. Responsible use and ongoing research are essential to preserve the efficacy of these vital medications.
